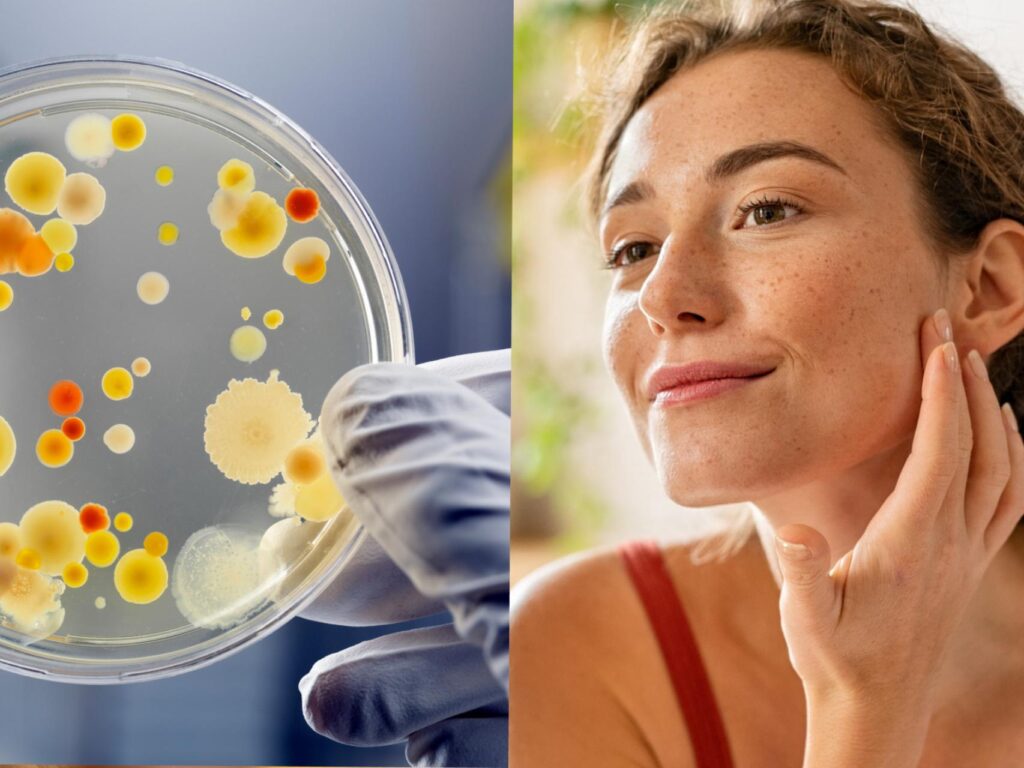
7 Psoriasis microbioma cutáneo

La integración entre el microbioma cutáneo y el metaboloma revela alteraciones funcionales relevantes en pacientes con psoriasis, sugiriendo que la disbiosis microbiana podría modular vías lipídicas, inflamatorias y de estrés oxidativo
Lugones Editorial©
Estudios recientes han demostrado alteraciones en el microbioma cutáneo de pacientes con psoriasis, incluyendo cambios en la abundancia de Cutibacterium, Staphylococcus y Corynebacterium. Sin embargo, las implicancias funcionales de estas variaciones microbianas en la patogénesis de la enfermedad permanecen poco caracterizadas.
En este contexto, un análisis multiómico integrado del microbioma y el metaboloma cutáneo en pacientes con psoriasis y controles sanos permite explorar la interacción entre comunidades microbianas y metabolismo del huésped, identificando posibles biomarcadores y nuevos blancos terapéuticos. Los hallazgos revelan redes de interacción microbioma–metaboloma que podrían desempeñar un papel relevante en la fisiopatología de la enfermedad.

Se requiere investigar acerca la compleja interacción entre la microbiota de la piel y el metabolismo del huésped en la patogénesis de la psoriasis
Introducción
La psoriasis es una enfermedad inflamatoria crónica cuya fisiopatología involucra múltiples factores aún no completamente dilucidados. En este contexto, el microbioma cutáneo emerge como un componente clave en la homeostasis de la piel y en la modulación de procesos inflamatorios.
Paralelamente, la desregulación metabólica ha sido reconocida como un elemento central en la psoriasis, con alteraciones en vías relacionadas con el metabolismo lipídico, de aminoácidos, energético y del estrés oxidativo, que contribuyen al ambiente inflamatorio y a la disfunción de la barrera cutánea.
Los avances en enfoques multiómicos han permitido integrar el análisis del microbioma con el perfil metabolómico, aportando una visión más completa del ecosistema cutáneo. Estas aproximaciones facilitan la identificación de interacciones entre microorganismos y metabolitos potencialmente implicadas en la patogénesis de la enfermedad.
En este sentido, la piel constituye un entorno dinámico donde microorganismos, células del huésped y metabolitos interactúan de manera constante. Alteraciones en este equilibrio podrían favorecer el desarrollo y la persistencia de enfermedades inflamatorias como la psoriasis.
Entre los microorganismos relevantes, Cutibacterium acnes ha sido asociado con la modulación del metabolismo lipídico cutáneo y con efectos antiinflamatorios, lo que refuerza su posible papel protector en este contexto.
Métodos
- Se realizó un estudio observacional que incluyó 29 pacientes con psoriasis en placa y 31 controles sanos, con distribución comparable de edad y sexo. El diagnóstico fue clínico e histopatológico cuando fue necesario. Se excluyeron factores potenciales de confusión como uso reciente de antibióticos o tratamientos inmunosupresores.
- Se recolectaron muestras de piel de áreas lesionales en pacientes y de sitios anatómicos comparables en controles.
- Microbioma cutáneo: hisopado estéril de superficie
- Metaboloma cutáneo: técnica de tape stripping
- Análisis del microbioma cutáneo
El ADN microbiano se extrajo de las muestras cutáneas y se realizó secuenciación del gen 16S rRNA (regiones V3–V4) mediante plataforma Illumina.
El procesamiento bioinformático incluyó:
. Control de calidad y filtrado de secuencias
. Asignación taxonómica (base SILVA)
. Análisis de diversidad alfa y beta
. Identificación de taxones diferenciales
. Correlación con la severidad clínica (PASI)
- Análisis metabolómico
Se realizó metabolómica no dirigida mediante LC-MS/MS a partir de muestras obtenidas por tape stripping.
El análisis incluyó:
. Detección y cuantificación de metabolitos
. Análisis multivariado (PCA, OPLS-DA)
. Identificación de metabolitos diferenciales (VIP > 1; q < 0,05)
. Análisis de vías metabólicas (KEGG)
. Correlación con PASI
- Análisis integrado microbioma–metaboloma
Se evaluaron las interacciones entre géneros bacterianos y metabolitos mediante:
. Análisis de correlación (Spearman/Pearson)
. Modelos multivariantes (CCA)
. Análisis de regresión para estimar contribuciones microbianas
Las asociaciones significativas se representaron mediante redes de interacción.

La piel constituye un entorno dinámico donde microorganismos, células del huésped y metabolitos interactúan de manera constante; alteraciones en este equilibrio podrían favorecer el desarrollo y la persistencia de enfermedades inflamatorias como la psoriasis
Resultados
Alteraciones en el microbioma cutáneo en psoriasis
El análisis del microbioma cutáneo evidenció una disminución de la riqueza bacteriana en pacientes con psoriasis, junto con diferencias significativas en la estructura global de la comunidad microbiana respecto de los controles sanos.
A nivel de género, se observó un enriquecimiento de Staphylococcus y Corynebacterium en lesiones psoriásicas, mientras que Cutibacterium se encontró significativamente reducido. También se detectó un aumento de Lawsonella y Kocuria.
Estas alteraciones mostraron correlación con la severidad clínica: Staphylococcus se asoció positivamente con el PASI, mientras que Cutibacterium lo hizo de forma inversa. En conjunto, estos hallazgos sugieren una disbiosis específica del microbioma cutáneo en psoriasis, vinculada con la actividad de la enfermedad.

Diferencias significativas en el microbioma de la piel entre los pacientes con psoriasis y los controles sanos
Perfil metabolómico diferencial en psoriasis
El análisis metabolómico reveló una clara separación entre pacientes y controles, identificándose 63 metabolitos significativamente alterados.
Las principales alteraciones involucraron:
- Metabolismo lipídico: aumento de fosfatidilcolinas, ceramidas y esfingolípidos
- Metabolismo de aminoácidos: incremento de metabolitos derivados de glutamato, arginina y triptófano, con disminución de serina y glicina
- Metabolismo energético: aumento de intermediarios del ciclo TCA
- Estrés oxidativo: disminución de glutatión reducido y aumento de su forma oxidada
- Mediadores inflamatorios: elevación de ácido araquidónico, prostaglandinas y leucotrienos
Varios de estos metabolitos se correlacionaron con la severidad clínica. Los mediadores inflamatorios mostraron asociaciones positivas con el PASI, mientras que metabolitos vinculados a la barrera cutánea (como ceramidas y vitamina D3) se correlacionaron de forma inversa.
El análisis de vías confirmó el enriquecimiento en rutas relacionadas con metabolismo lipídico, ácido araquidónico y estrés oxidativo.

El perfil metabolómico revela distintas firmas metabólicas en la psoriasis
Interacción microbioma–metaboloma
El análisis integrado evidenció redes complejas de interacción entre bacterias y metabolitos.
Cutibacterium mostró correlaciones negativas con metabolitos lipídicos inflamatorios, mientras que Staphylococcus y Corynebacterium se asociaron positivamente con mediadores inflamatorios y alteraciones lipídicas, sugiriendo su participación en procesos inflamatorios y disfunción de la barrera cutánea.
Asimismo, se observó una asociación positiva entre bacterias de la familia Propionibacteriaceae y niveles de glutatión, lo que vincula la disbiosis con mecanismos de estrés oxidativo.
Los análisis multivariantes confirmaron estos patrones, mostrando agrupamiento de Cutibacterium con metabolitos antioxidantes, y de Staphylococcus y Corynebacterium con perfiles proinflamatorios.
En conjunto, estos resultados indican que la disbiosis del microbioma cutáneo en psoriasis se asocia con una desregulación coordinada de vías metabólicas, particularmente aquellas relacionadas con lípidos, inflamación y estrés oxidativo.

Análisis de correlación entre el microbioma de la piel y el metaboloma en la psoriasis
Discusión
Este estudio aporta evidencia de que la disbiosis del microbioma cutáneo en psoriasis no solo implica cambios en la composición bacteriana, sino que se asocia con alteraciones funcionales del metabolismo cutáneo. La integración microbioma–metaboloma permite avanzar desde una descripción taxonómica hacia una comprensión mecanicista de la enfermedad.
La reducción de Cutibacterium y el aumento de Staphylococcus y Corynebacterium refuerzan un patrón de disbiosis previamente descrito, pero aquí se vinculan con funciones biológicas específicas. En particular, la disminución de bacterias comensales podría comprometer mecanismos protectores relacionados con el metabolismo lipídico, la regulación inflamatoria y la defensa antioxidante, mientras que el enriquecimiento de géneros potencialmente proinflamatorios podría amplificar estas vías.

La disbiosis del microbioma cutáneo en psoriasis no solo implica cambios en la composición bacteriana, sino que se asocia con alteraciones funcionales del metabolismo cutáneo
En paralelo, las alteraciones metabolómicas observadas sugieren una reprogramación metabólica cutánea, con impacto en la integridad de la barrera, la inflamación y el estrés oxidativo. La integración de ambos niveles revela redes coordinadas en las que determinados microorganismos se asocian con perfiles metabólicos proinflamatorios o protectores, aportando un modelo funcional de interacción huésped–microbioma.
Un hallazgo particularmente relevante es la asociación entre bacterias comensales y mecanismos antioxidantes, lo que sugiere que la disbiosis podría contribuir a la enfermedad también a través de la pérdida de capacidad de defensa frente al estrés oxidativo.
Conclusiones
El análisis integrado del microbioma y el metaboloma cutáneo demuestra que la psoriasis se asocia con una desregulación coordinada de comunidades microbianas y vías metabólicas.
Estos resultados apoyan un modelo en el que la disbiosis cutánea no solo refleja la enfermedad, sino que podría participar activamente en su fisiopatología mediante la modulación del metabolismo lipídico, las respuestas inflamatorias y el estrés oxidativo.
El análisis integrado del microbioma y el metaboloma emerge así como una herramienta clave para identificar biomarcadores y potenciales blancos terapéuticos, abriendo nuevas perspectivas en el abordaje de esta enfermedad.
El análisis integrado del microbioma y el metaboloma emerge así como una herramienta clave para identificar biomarcadores y potenciales blancos terapéuticos, abriendo nuevas perspectivas en el abordaje de esta enfermedad
Psoriasis y microbioma cutáneo
Fuente
Wu F, Jiang X, Chen G, Zhang L. Integrated microbiome and metabolome analysis reveals Microbial-Metabolic interactions in psoriasis pathogenesis. BMC Microbiol 2025 Oct 17;25(1):665.








